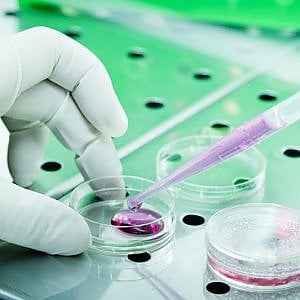
Ricerca: in prova un nuovo farmaco blocca ‘travestimento’ cellule malate

Il Direttore dell’Area Marina Protetta “Regno di Nettuno” Antonio Miccio intervenendo sulla vicenda dei gamberetti ha dichiarato:“Allo stato attuale non si hanno ancora notizie ufficiali sulle cause del fenomeno ma dai campioni prelevati per le analisi (a cura della Stazione zoologica Anton Dorhn) sembrerebbe si tratti di krill mediterraneo, specie di cui i canyon sottomarini sono ricchissimi. Questa specie va incontro a migrazioni notturne e spesso, a causa di forti correnti, una parte dei banchi può essere trasportata verso riva e finire spiaggiata. Ovviamente non mangiateli”.
“Nei fondali dell’Area Marina Protetta Regno di Nettuno sono presenti particolari conformazioni geologiche che degradano in veri e propri canyon sottomarini in più punti. Proprio davanti la spiaggia di San Montano a circa 1-1,5 miglia si aprono le testate del complesso del canyon di Cuma, zona particolarmente frequentata da cetacei e per tale motivo definita come zona D di protezione dell’AMP (di salvaguardia dei mammiferi marini) che qui trovano condizioni favorevoli di nutrimento”.
“Tali caratteristiche particolari non sono note alla maggior parte della popolazione ma si sta cercando di ampliarne la conoscenza il più possibile – ha proseguito Miccio – anche attraverso nuovi canali di comunicazione, come il portale di citizen science dell’AMP (www.citizensciencerdn.org) su cui sono stati segnalati sia lo spiaggiamento straordinario di gamberetti dei giorni scorsi che lo spiaggiamento del capodoglio avvenuto la mattina del 24/12/2018.
“In attesa di riscontri ufficiali, questa tesi sembra la più attendibile a spiegare il massiccio spiaggiamento avvenuto”.